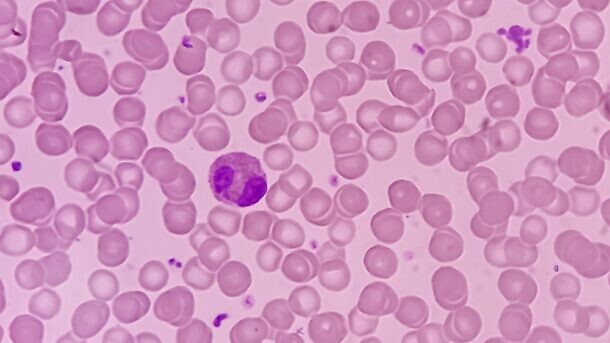

חוקרים מארצות-הברית בנו מודל פרמקוקינטי על הטיפול עם אזציטידין, אשר הדגים כי המשטר המוצע לטיפול, כולל לוח הזמנים והמינון, מאוזן מבחינת התועלת הטיפולית והסיכון הבטיחותי
טיפול אחזקה עם אזציטידין במתן פומי (Oral-AZA) מאושר לטיפול במבוגרים הסובלים מלוקמיה מיאלואידית חריפה (AML) בתקופת ההפוגה לאחר כימותרפיה אינטנסיבית, אשר לא ממשיכים להשתלת תאי גזע המטופואטיים.
במחקר שממצאיו פורסמו בכתב-העת ‘Clinical Pharmacology & Therapeutics’ מטרת החוקרים הייתה לפתח מודל פרמקוקינטי של אוכלוסייה (PopPK: population pharmacokinetic) על מנת לאפיין את פרופילי הריכוז-זמן של Oral-AZA בקרב חולי AML, תסמונת מיאלודיספלסטית או לוקמיה מיאלומונוציטית כרונית. פרמטרים של חשיפה משוערי PopPK שימשו את החוקרים להערכת קשרי חשיפה-תגובה במחקר פאזה 3 QUAZAR AML-001.
מערך הנתונים של ה- PopPK כלל 286 מטופלים בסך הכל, עם 1,933 רישומים של ריכוז ה- oral-AZA הניתנים להערכה. מודל ה-PopPK הסופי היה מודל בעל מדור אחד (one-compartment) עם ספיגה מסדר ראשון (first-order absorption) המשלב את זמן ההשהיה של הספיגה וסילוק מסדר ראשון (first-order elimination).
אנליזות הרגרסיה שערכו החוקרים זיהו שני פרמטרים של חשיפה ל- oral-AZA (area under the plasma concentration–time curve at steady state (AUCss); maximum plasma concentration (Cmax)) כמנבאים מובהקים סטטיסטית לשרידות ללא הישנות (יחס סיכונים 0.521, P < 0.001; יחס סיכונים 0.630, P = 0.013, בהתאמה), ו- AUCss כגורם מנבא מובהק לשרידות כוללת (יחס סיכונים 0.673, P = 0.042).
ההסתברות לנויטרופניה בדרגה ≥ 3 הייתה גבוהה יותר באופן מובהק בעת עלייה ב- AUCss(יחס הסיכויים 5.71, רווח בר-סמך של 95% 2.73-12.62, P < 0.001), AUC מצטבר במעגלים 1 עד 6 (יחס הסיכויים 2.71, רווח בר-סמך של 95% 1.76–4.44, P < 0.001), ו- Cmax ב- steady-state (יחס הסיכויים 2.38, רווח בר-סמך של 95% 1.23–4.76, P = 0.012). בנוסף, זוהתה מגמת ירידה בין ה- AUCss לבין הרחבות לוח הזמנים עם קשר להישנות, וזאת לעומת מגמת עלייה בין ה- AUCss לבין הפחתות המינון עם קשר לאירועים.
החוקרים מסכמים כי משום שמרבית החולים (56.8%) לא נזקקו לשינויים במינון, והשיעורים שנזקקו להארכת לוח הזמנים (19.4%) או להפחתת המינון (22.9%) היו כמעט שווים, הטיפול עם oral-AZA פעם ביום במינון 300 מיליגרם למשך 14 ימים נמצא כמשטר הטיפולי האופטימלי מבחינת לוח זמנים ומינון, באופן המאזן בין התועלת הטיפולית ובין הסיכון הבטיחותי.
למקור: